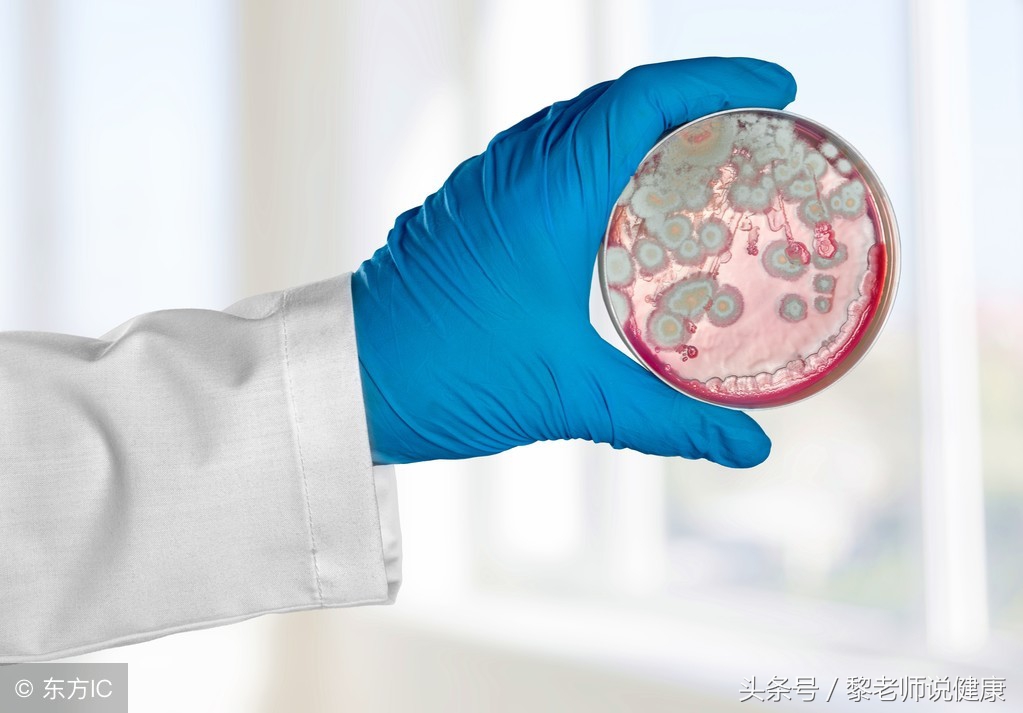
风油精原来有18个奇妙用处,中国神药风油精还有什么

在日常生活中,我们几乎会随身携带一小瓶风油精,偶尔遇到什么小事情好像都能用风油精解决比如说长时间坐车导致的头晕胸闷、夜间出门被蚊虫叮咬的患处、平时工作时的提神神器等等...

但是其实风油精的用处远远不止这些,它可以说是万能神药,我们所认知的仅仅是风油精的冰山一角。如果你不相信的话,接下来我想问你们一个问题,你们知道风油精其实是可以喝的吗?

风油精竟然可以口服???
#真相来了#
首先风油精的主要成分包括:桉叶、薄荷脑、香精油等...其中唯一樟脑这一物质具有一定毒性外,其他都是对人体有百利而无一害的药物成分,而在除孕妇外的正常人体内磷酸脱氢酶的作用下会迅速转化为无毒物质。所以不要被它辛辣的外感所吓到,它其实真的是可以服用的,并且对于咽喉疼痛有很大的功效。但是口服需要注意方法,一定不能与水冲服并且只能任其顺着食道流入,效果极好。口服的风油精还可预防口臭,是口臭人群的又一福音。

风油精还有一些少数人才知道的妙用
比如说可以治疗足癣:足癣是小病,但是奇痒无比,给人体带来的痛苦可比大病,除用脚气药膏外还可在夜间温水泡脚之后,涂抹一定风油精在患处,溃烂处疼痛缓解,伤口在两三天后即可见好。

脚气,痒
还可祛湿止痛:女性经期在腹部涂抹一定风油精后用手腹缓慢按摩,手腹的温度加之风油精具有奇效,可去除宫内寒气,宫内寒气是造成痛经的主要原因之一,所以风油精对痛经也有一定作用。

痛经
治冻疮:局部可以起到一定活血化瘀的功效,预防冻疮的发生。
治痔疮:于处理干净的肛周涂抹一滴风油精,可缓解痔疮的痛感。
预防中暑和感冒:夏季出门前可于太阳穴处并轻轻按压,可对中暑有良好的防御功效。

感冒
除了以上的药用功效以外还有一些可用于日常生活中的小妙招
比如说可以在衣物上滴几滴风油精不仅可以去除汗臭狐臭还可以杀菌抑菌,还可使用在内用衣物上防止细菌的滋生,预防阴道的细菌感染。
细菌
去腥:生活中不免因为一些原因接触到腥味重的东西,而我们也常因为手上去除不掉的腥味苦恼,只要一点点风油精擦擦手就可以达到去腥的目的啦。
去污:一些顽固的污渍也可以用风油精去除,特别是胶水印等。

其实风油精还有很多神奇的功效等着我们去实践和发现,以上的列举只是个人觉得会对生活有益的方面。现在这种夏季里还可以在温水浴中加入风油精,能很好的预防痱子风油精对于小伤小病来说确实具有很强的实用性,所以建议每个人的家中或者身边都常备有风油精。

风油精在手,天下我有!
但要注意的是孕妇和婴儿切忌使用风油精,因婴儿和孕妇身体内缺少多种酶类物质而无法中和樟脑中的有毒成分,容易导致身体发生全身性的中毒现象甚至严重的超敏反应。
此文系临床医学生撰写,请勿随意复制!
养生就在生活中,更多健康资讯请关注黎老师说健康!